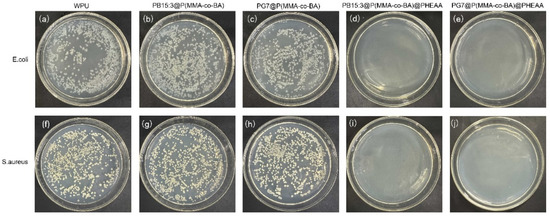
Coatings 13 01114 g007 550

More news
- International Process Plants (IPP) enters agreement to market ammonia, methanol and melami...
- New high-throughput device to unlock the potential of advanced materials
- 2024 AI in European Manufacturing Report: European manufacturers optimistic about AI but s...
- Britt Meelby Jensen nominated to Hempel A/S Board of Directors
- Masterpress commits to set science-based targets for greenhouse gas emissions reduction

Phthalocyanine pigments have many problems in waterborne coating applications because of their low polarity, poor dispersion in water, and easy agglomeration properties. In order to solve these problems, the phthalocyanine pigments were encapsulated with a copolymer of methyl methacrylate (MMA) and butyl acrylate (BA) by a mini-emulsion polymerisation method.
The pigments are effectively dispersed in water and have good compatibility with the resin. Concerning the bacterial reproduction and growth problem for the waterborne system, the resin-encapsulated phthalocyanine pigments were further grafted with antibacterial polymer poly(N-(2-hydroxyethyl) acrylamide) (PHEAA) on its surface using the photoemulsion polymerisation technique.
Comprehensive properties, including centrifugal stability and chromaticity change, were studied. The polymer encapsulation improved the centrifugal stability of the pigment. The thermogravimetric results showed that the residual mass of C.I. Pigment Green 7 (52.30%) was higher than that of C.I. Pigment Blue 15:3 (30.06%), and the sublimation fastness of PG7 was higher. The TEM results revealed that the shape of the PG7 after encapsulation and grafting was more regular than that of PB15:3. The L* of the pigment decreased after encapsulation but then increased after further grafting. The phthalocyanine pigment composite latex had good antibacterial properties after the grafting of PHEAA.
 Organic pigments have excellent colour expressiveness, photosensitivity, tinting power and vivid colour properties. Thus, they are widely used in fabric printing and dyeing, inkjet printing, paint preparation, and many other applications [1,2,3]. On the other hand, the drawbacks of organic pigments, such as their poor dispersion, weak weathering resistance, poor stability, uneven particle size and easy agglomeration properties, limit the application of organic pigments in many fields such as waterborne coatings [4,5]. The commonly used blue organic pigments are mainly phthalocyanine pigments. Phthalocyanine pigments are aromatic macrocyclic organic compounds with eighteen-π electronically stable conjugated aromatic systems. Phthalocyanine itself does not have color, but it can be dissolved in suitable solvents at high temperatures and complexed with heavy metal salts to form macromolecular complexes with bright colours.
Organic pigments have excellent colour expressiveness, photosensitivity, tinting power and vivid colour properties. Thus, they are widely used in fabric printing and dyeing, inkjet printing, paint preparation, and many other applications [1,2,3]. On the other hand, the drawbacks of organic pigments, such as their poor dispersion, weak weathering resistance, poor stability, uneven particle size and easy agglomeration properties, limit the application of organic pigments in many fields such as waterborne coatings [4,5]. The commonly used blue organic pigments are mainly phthalocyanine pigments. Phthalocyanine pigments are aromatic macrocyclic organic compounds with eighteen-π electronically stable conjugated aromatic systems. Phthalocyanine itself does not have color, but it can be dissolved in suitable solvents at high temperatures and complexed with heavy metal salts to form macromolecular complexes with bright colours.

With the purpose of solving the problem of low polarity and insolubility of phthalocyanine pigments, the surface of PB15:3 is usually modified by adding dispersants. To obtain a more stable system, Hakeim [8] used three different dispersants, anionic emulsifier sodium dodecyl sulfate (SDS), cationic emulsifier hexadecyl trimethyl ammonium bromide (CTAB), and nonionic emulsifier Egyptol BLM (based on nonyl phenol ethoxlate), to modify the surface of PB15:3, respectively. A comprehensive comparison showed that the particle size modified with SDS was smaller, and the particle size did not change with time, indicating a good long-term stability. Additionally, Hakeim [9] et al. compared the dispersion stability of three pigments with different structures, i.e., C.I. Pigment Green 7, C.I. Pigment Yellow 17, and C.I. Pigment Orange 5. They found that the low polarity brought by the eight aromatic rings in PG7 increased hydrophobicity and led to increased interaction with the dispersants, resulting in higher dispersion stability. He [10] et al. synthesized a carboxylate comb copolymer (St-AAMA-PEG) for pigment dispersion and found that the best properties and the smallest particle size could be obtained when PEG600 was used.
READ MORE:
Focus on pigments: Shining Brite! High performance aluminium effect pigments
Although the pigment can be effectively dispersed in water by using suitable dispersants, it has poor dispersion stability against mechanical vibrations and is prone to aggregation and settling [11]. Furthermore, the dispersant’s dose is high, resulting in adverse effects such as poor water and weather resistance. In order to solve the above problems, the pigment could be encapsulated with resin instead of isolated dispersants. Li [12] et al. prepared a fluorescent pigment latex (FPL) by mini-emulsion polymerisation using P(MMA-co-BA) encapsulated with fluorescein. Fluorescent pigment latex (FPL) could effectively improve the hand feel and rubbing fastness of cotton fabrics. Wen [13] et al. prepared three-colour ink particles by mini-emulsion polymerization and found that the ink system was stable, with a uniform particle size and a high Zeta potential. The presence of a polystyrene shell could effectively improve the aging resistance of pigments.
For waterborne application systems containing organic pigments, antibacterial agents are generally added to avoid the growth and reproduction of bacteria, which leads to spoilage, demulsification and decreases in the stability properties and service lives of the products. An antibacterial component is introduced typically by the simple physical mixing method, which is convenient and efficient. Zhao [14] et al. prepared coatings by incorporating a synthetic quaternary ammonium methacrylate compound (QAC-2) into a copolymer of methyl methacrylate (MMA) and ethylene glycol dimethacrylate (EGDMA). The antibacterial properties of the coating against Gram-negative Escherichia coli (E. coli) and Gram-positive Staphylococcus epidermidis (S. epidermidis) were good. Shevtsova [15] et al. modified halogenated nanotubes (HNTs) with a poly(oligo(ethylene glycol)ethyl ether methacrylate) (POEGMA) brush, and then silver nanoparticle was loaded. This nanomaterial had a good temperature sensitivity effect and could be used in antibacterial applications, especially in biomedical fields. Liu [16] et al. used Ag as the antibacterial nanoparticle immobilized in spherical polyelectrolyte brushes (SPB) composed of poly(N-vinylcarbazole) (PVK) cores and poly (acrylic acid) PAA chain layers. They found that the prepared coatings had good stability and antibacterial properties, but their inhibition time was relatively short, with only 24hr.
Compared with the physical mixing method, the structural antibacterial method is gaining attention and popularity. The antibacterial component is introduced into the resin surface by chemical reaction or coupling. The sustainability of antibacterial effect is better due to well improved distribution of antibacterial component. Furthermore, fewer VOCs (volatile organic compounds) are released since the antibacterial structure cannot be evaporated after film formation. Among the various structural antibacterial structures, quaternary ammonium compounds (QACs) are mostly applied. Usually, QACs kill bacteria by penetrating their alkyl chains into the microbial membrane and changing the phospholipid bilayer, which causes membrane damage and leads to leakage of intracellular components, thus achieving the effect of sterilisation [17,18,19]. Yan [20] et al. prepared a diblock polymer brush on silicon wafers (Si-g-PEGMA-PDMAEMA), and this sample was subjected to quaternisation. The observation of bacterial morphology by SEM showed that the quaternized Si-g-PEGMA-PDMAEMA was able to kill bacteria (E. coli and S. aureus) effectively. Liu [21] et al. prepared polymer brushes consisting of the poly (hydroxyethyl methacrylate) (PHEMA) outer layer and the anionic inner layer loaded with cationic antibacterial peptide (AMP), which can effectively inhibit bacterial adhesion and kill bacteria by exposure to positively charged amines. Ng [22] et al. prepared a brush library by a high-throughput method using the surface-initiated photoinduced electron transfer-reversible addition-fragmentation chain transfer polymerization (SI-PET-RAFT) method to effectively tune the degree of attachment of Gram-negative Pseudomonas aeruginosa (PA) biofilms. Recently, a new type of antibacterial polymer, poly(N-(2-hydroxyethyl) acrylamide (PHEAA), was selected to repel biomolecules, including proteins and bacteria, based on a physical barrier from a hydrated layer [23]. In our previous work, it was also reported that the brush structure, based on PHEAA, provides high antifouling performance, which is also useful to bacteria resistance [24].
Results and discussion
Preparation of Pigment Composites Latexes


Preparation of functionalised composite latexes


Figure 4d shows the morphology of PG7, which has a very irregular shape and is mainly composed of fine particles of PG7 agglomerated in the shape of elliptical rods, with uneven particle sizes. Figure 4e shows the TEM image of PG7 after encapsulating with P(MMA-co-BA). It has an irregular spherical shape, with a particle size of about 150 nm, and no agglomerated PG7 particles can be seen anymore. Figure 4f shows a more regular spherical shape and an evident core–shell structure for PG7@P(MMA-co-BA)@PHEAA. The particle size increases significantly, further confirming the successful grafting of PHEAA onto the surface of PG7@P(MMA-co-BA). The DLS results show that the particle size increased from 148 nm to 185 nm after PHEAA grafting. It is also found that the size is larger for both pigments in TEM compared to DLS results, which is mainly due to the wide distribution of original size of pigments, as shown in Figure 4a,d, and the TEM shown here is not a statistical size.
The shape of PG7 after being encapsulated by P(MMA-co-BA) was more regular than that in the PB15:3 case, which was mainly due to the more uniform size of the unencapsulated PG7. Therefore, PG7 was more likely to form a more regular spherical shape during the encapsulation process, which was consistent with the PDI (polydispersity index) results (The PDI values of PB15:3 and PG7 were 0.302 and 0.231, respectively).
READ MORE:
Focus on sustainability: Challenges in selecting bio-based dispersing additives for latex paints

Figure 5b shows the thermogravimetric plots of PG7, PG7@P(MMA-co-BA), and PG7@P(MMA-co-BA)@PHEAA. For PG7, the mass loss was 30.5% at 440 °C to 647 °C, mainly due to the decomposition of the aromatic conjugated macrocycles. For PG7@P(MMA-co-BA), the mass loss was 88.6% at 341 °C to 474 °C. This could have been mainly attributed to the thermal decomposition of P(MMA-co-BA) and contained some degradation of the PG7 during the thermal decomposition process. For PG7@P(MMA-co-BA)@PHEAA, the mass loss was 84.0% between 216 °C and 491 °C, which was mainly due to the thermal decomposition of the PHEAA and P(MMA-co-BA).
From Figure 5a,b, it can be found that the residual masses of PB15:3 and PG7 are 30.1% and 52.3% after heating to 800 °C, respectively. It can be clearly seen that the residual mass of PG7 is higher after thermal decomposition, which is attributable to the presence of Cl atoms at the periphery of the PG7 structure. After encapsulation, the residual mass is 3.10% for the PB15:3 case and 3.85% for the PG7 case. The calculated pigment content is 10% and 8% for PB15:3 and PG7, respectively, which is close to the feed ratio of pigment to resin as 10% in mass. Furthermore, it is evident from Figure 5a,b that the thermal decomposition onset temperatures of PB15:3 and PG7 are lower after encapsulating with P(MMA-co-BA). After the grafting of the PHEAA, the thermal decomposition onset temperature is further reduced. A drop is found before 300 °C in Figure 5b; the mass loss may be ascribed to the oligomer from the previous steps.
Chromaticity of functionalised composite latexes

Antibacterial performance of functionalised composite latexes